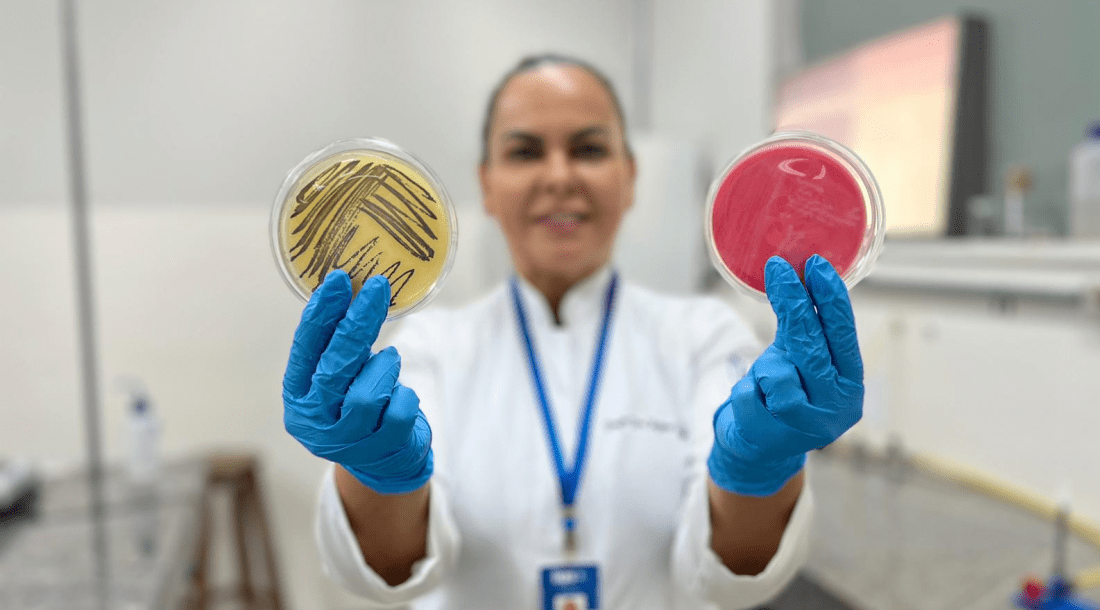
itps

O Carnaval é um período de festa e diversão, mas também exige atenção especial com a saúde, principalmente no consumo de alimentos e bebidas. O Instituto Tecnológico e de Pesquisas do Estado de Sergipe (ITPS), vinculado à Secretaria de Estado do Desenvolvimento Econômico e da Ciência e Tecnologia (Sedetec), alerta para os riscos de surtos alimentares e intoxicações que podem estragar a folia e trazer diversas doenças.
A microbiologista do ITPS, Rejane Batista, alerta que o calor favorece a multiplicação de bactérias como Salmonella, Escherichia coli e Staphylococcus aureus, que podem causar infecções gastrointestinais. “É fundamental escolher alimentos de locais que apresentam condições higiênico-sanitárias seguras e evitar carnes, laticínios e maioneses expostos ao calor por muito tempo. Além disso, a higiene dos manipuladores e do ambiente deve ser observada para prevenir contaminações”, destaca.
A hidratação é fundamental durante o Carnaval, mas é preciso cuidado com a escolha das bebidas e da água consumida. “Se manter hidratado é essencial, mas é importante escolher bem o que beber. Sempre opte por água potável e evite o consumo de água de torneiras públicas ou fontes sem garantia de qualidade”, informa a microbiologista.
Ela também alerta para o risco do gelo contaminado, que pode comprometer a segurança dos drinks e sucos. “O gelo filtrado é mais transparente e feito com água tratada, enquanto o gelo não filtrado costuma ser opaco ou esbranquiçado, pois contém impurezas e gases dissolvidos”, orienta.
Para quem pretende se refrescar em piscinas, a microbiologista do ITPS reforça a importância de verificar se a manutenção da água está em dia e se o tratamento com cloro e algicidas foi realizado corretamente. Piscinas superlotadas devem ser evitadas, pois o grande número de pessoas aumenta a possibilidade de contaminação da água por suor, fezes, urina e outras excreções ou substâncias nocivas à saúde.
Além disso, águas turvas podem ser um indicativo de que o tratamento não está adequado. Segundo Rejane, outro ponto fundamental é evitar engolir a água da piscina, pois, mesmo tratada, ela pode conter patógenos que causam infecções gastrointestinais.
Nas praias, a qualidade da água pode variar, especialmente em períodos de alta movimentação. “Antes de entrar no mar, é importante verificar boletins de balneabilidade, pois os órgãos ambientais costumam divulgar informações sobre a condição das águas. Além disso, após chuvas fortes, o risco de contaminação aumenta, já que resíduos e esgoto podem ser arrastados para o mar”, orienta a especialista. Ela ainda ressalta que atitudes simples, como não urinar ou descartar lixo na água ajudam a evitar a proliferação de microrganismos nocivos e contribuem para a preservação ambiental.
Após o contato com a água, alguns cuidados são essenciais para evitar doenças. Rejane orienta que lavar bem as mãos e o rosto ao sair da praia ou da piscina, especialmente antes das refeições, ajuda a reduzir os riscos de contaminação. Além disso, pessoas com feridas abertas devem evitar nadar, pois a água contaminada pode causar infecções.
Para um Carnaval seguro, a especialista recomenda adotar hábitos simples, como higienizar as mãos sempre que possível, evitar o consumo de alimentos de origem duvidosa e não compartilhar bebidas, já que isso pode facilitar a transmissão de doenças. “Se após a folia surgirem sintomas como vômito, diarreia ou febre, é essencial buscar ajuda médica imediatamente”, reforça Rejane.
Serviço
O Laboratório de Microbiologia do ITPS realiza as análises necessárias para o controle da qualidade dos alimentos. Para solicitar a análise do instituto, é necessário buscar o Serviço de Atendimento ao Cliente (SAC) presencialmente na rua Vila Cristina, bairro 13 de Julho em Aracaju; por meio dos telefones (79) 3198-8811 e 99191-3042; ou pelo e-mail sac@itps.se.gov.br.
Fonte: Governo de SE